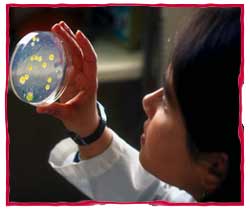

Adka Laboratories
Environmental Services
| |
| Home |
| Service |
| Products |
| About Us |
| Contact |
| About Adka Lab |
The primary goal of Adka is consumer protection. Our mission is to provide our customers with the highest level of service, so that inturn, they can produce best possible product. Adka stands behind our products and services and walks step by step beside our customers throughout the entire production process to assure both the quality of their products and their upmost satisfaction. Adka is committed to quality and therefore is associated with numerous laboratories locally and internationally. Adka Laboratories is a member of the Caribbean Water and Waste Water Association, the Southern Drilling Association and the Water Quality Association. Adka Laboratories is also affiliated with Advanced Water Engineering Inc. and Consolidated Environmental Engineering. Locally, Adka Laboratories works in conjunction with the Bahamas' Ministry of Health and the Ministry of Environmental Health Service attests to Adka’s competency in the maintenance and monitoring of water and wastewater systems, and the quality control monitoring of consumer product facilities.
|